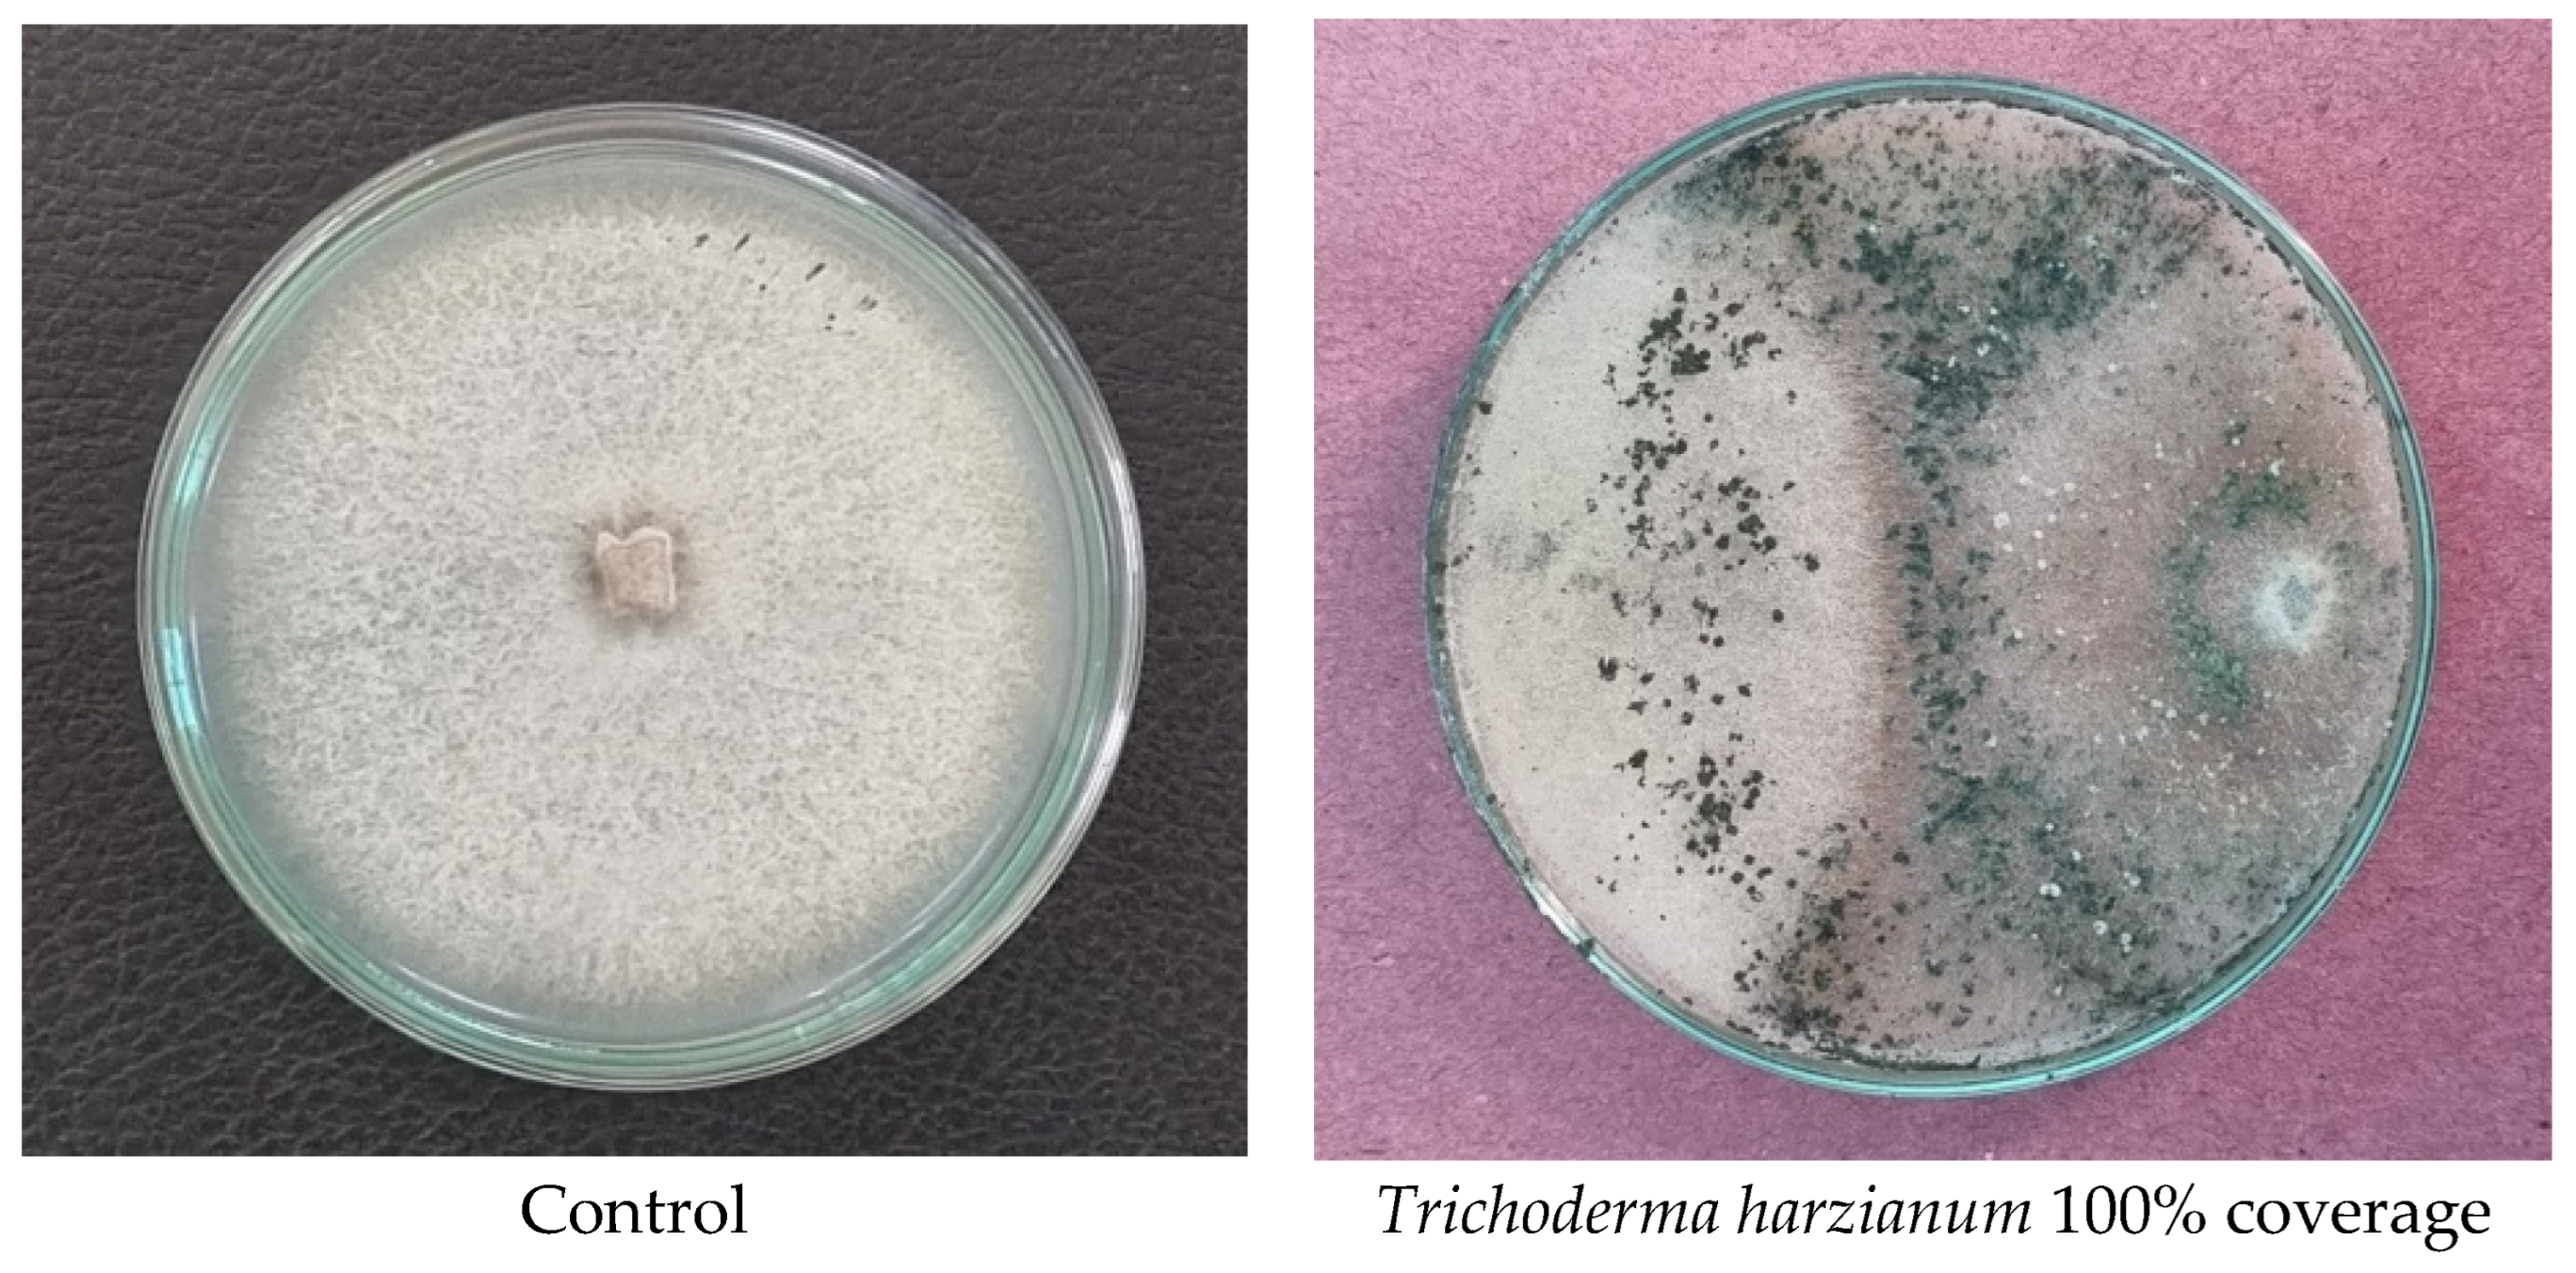
Pathogens 14 00544 g013

Identification, Detection, and Management of Soft Rot Disease of Ginger in the Eastern Himalayan Region of India
Abstract
1. Introduction
2. Materials and Methods
2.1. Description of the Study Area
2.2. Planting Materials
2.3. Weather
2.4. Soil Chemical Properties
2.5. Experimental Design and Treatments
2.6. Evaluation of Parameters
2.7. Isolation and Characterisation of Pathogenic Fungi
2.8. Molecular Identification
2.9. Evolutionary Relationships of Taxa
2.10. Bioefficacy of Different Treatments Against the Test Pathogen
| Class 1 | The T. harzianum completely overgrew the P. aphanidermatum (100% overlap) |
| Class 2 | The T. harzianum overgrew at least 2/3 of P. aphanidermatum (75% overlap) |
| Class 3 | The T. harzianum overgrew at least ½ of P. aphanidermatum (75% overlap) |
| Class 4 | The P. aphanidermatum and the T. harzianum locked at the point of contact |
| Class 5 | The P. aphanidermatum overgrew the T. harzianum. |
| The interaction was observed regularly until 9 days after contact. | |
2.11. Pathogenicity Test
2.12. Rhizome Yield Analysis
2.13. Rhizome Yield Loss Estimation
2.14. Economic Appraisal
2.15. Statistical Analysis
3. Results
3.1. Disease Symptoms
3.2. Identification of the Pathogen
3.3. Pathogenicity Test
3.4. Rhizome Germination (%)
3.5. Plant Height
3.6. Disease Incidence
3.7. Disease Severity
3.8. Soil Chemical Properties
3.9. Bioefficacy of Different Treatments Against the Test Pathogen
3.10. CODEX
3.11. Rhizome Yield
3.12. Economic Appraisal
4. Discussion
5. Conclusions
Supplementary Materials
Author Contributions
Funding
Institutional Review Board Statement
Informed Consent Statement
Data Availability Statement
Acknowledgments
Conflicts of Interest
References
- Baby, A.S.; Menon, J.S.; Ashwini, S. Yield improvement in transplanted ginger by seed priming and foliar spray of chitosan. Med. Plants-Int. J. Phytomedicines Relat. Ind. 2023, 15, 361–368. [Google Scholar] [CrossRef]
- Spence, C. Ginger: The pungent spice. Int. J. Gastron. Food Sci. 2023, 33, 100793. [Google Scholar] [CrossRef]
- Anonymous. FAOSTAT Statistical Database, Food and Agricultural Organization: Rome, Italy. 2020. Available online: http://www.fao.org/faostat/en/ (accessed on 2 February 2021).
- Giri, N.C.; Mohanty, R.C. Traditional versus underneath farming of turmeric and ginger in Odisha, India. Int. J. Agric. Stat. Sci. 2022, 18, 189–195. [Google Scholar]
- Anonymous. National Horticulture Board, 2021–2022. 2020. Available online: https://agriexchange.apeda.gov.in/ (accessed on 22 February 2023).
- Islam, M.M.; Khatun, F.; Faruk, M.I.; Rahman, M.M.; Hossain, M.A. Incidence of rhizome rot of ginger in some selected areas of Bangladesh and the causal pathogens associated with the disease. Bangladesh J. Agric. Res. 2019, 44, 569–576. [Google Scholar] [CrossRef]
- Bhat, A.I.; Naveen, K.P.; Pamitha, N.S.; Pant, R.P. Association of two novel viruses with chlorotic fleck disease of ginger. Ann. Appl. Biol. 2020, 177, 232–242. [Google Scholar] [CrossRef]
- Mishra, R.S.; Pandey, V.P. Effect of integrated nutritional supplement on the soft rot, growth and yield of ginger. Plant Arch. 2015, 15, 47–49. [Google Scholar]
- Das, A.; Dey, U. Controlling rhizome rot in ginger. The Hindu, 18 February 2015. [Google Scholar]
- Kumar, A. Diseases of Ginger and Turmeric. In Handbook of Spices in India: 75 Years of Research and Development; Ravindran, P.N., Sivaraman, K., Devasahayam, S., Babu, K.N., Eds.; Springer: Singapore, 2024; pp. 3675–3707. [Google Scholar] [CrossRef]
- Poudyal, B.K. Jeevatu: One of the best bio-agents for the control of soft rot of ginger. In Proceedings of the 2nd International Conference on Environment Science and Biotechnology, Kuala Lumpur, Malaysia, 22–23 December 2012; Volume 48, pp. 66–70. [Google Scholar]
- Das, M.M.; Haridas, M.; Sabu, A. Biological control of black pepper and ginger pathogens, Fusarium oxysporum, Rhizoctonia solani and Phytophthora capsici, using Trichoderma spp. Biocatal. Agric. Biotechnol. 2019, 17, 177–183. [Google Scholar]
- Mozumder, A.B.; Chanda, K.; Chorei, R.; Prasad, H.K. An evaluation of aluminum tolerant Pseudomonas aeruginosa A7 for in vivo suppression of fusarium wilt of chickpea caused by Fusarium oxysporum f. sp. ciceris and growth promotion of chickpea. Microorganisms 2022, 10, 568. [Google Scholar] [CrossRef]
- Yogalakshmi, S.; Thiruvudainambi, S.; Kalpana, K.; Thamizh Vendan, R.; Oviya, R. Antifungal activity of Trichoderma atroviride against Fusarium oxysporum f. sp. lycopersici causing wilt disease of tomato. J. Hortic. Sci. 2021, 16, 241–256. [Google Scholar]
- Paranthaman, L.; Seethapathy, P.; Pandita, D.; Gopalakrishnan, C.; Sankaralingam, S.; Venkatesh, S.; Malaisamy, A.; Pandita, A.; Casini, R.; Alataway, A.; et al. Levering proteomic analysis of Pseudomonas fluorescens mediated resistance responses in tomato during pathogenicity of Fusarium oxysporum f. sp. oxysporum. Front. Sustain. Food Syst. 2023, 7, 1157575. [Google Scholar] [CrossRef]
- Ramírez-Valdespino, C.A.; Casas-Flores, S.; Olmedo-Monfil, V. Trichoderma as a model to study effector-like molecules. Front. Microbiol. 2019, 10, 1030. [Google Scholar] [CrossRef] [PubMed]
- Zhang, N.; Wu, J.; Zhang, S.; Yuan, M.; Xu, H.; Jie, L.; Zhang, P.; Wang, M.; Kempher, M.L.; Tao, X.; et al. Molecular basis for coordinating secondary metabolite production by bacterial and plant signaling molecules. J. Biol. Chem. 2022, 298, 102027. [Google Scholar] [CrossRef] [PubMed]
- Kumari, N.; Srividhya, S. Secondary metabolites and lytic tool box of Trichoderma and their role in plant health. In Molecular Aspects of Plant Beneficial Microbes in Agriculture; Sharma, V., Salwan, R., Tawfeeq Al-Ani, L.K., Eds.; Elsevier: Amsterdam, The Netherlands, 2020; pp. 305–320. [Google Scholar]
- Prabhukarthikeyan, S.R.; Raguchander, T. Antifungal metabolites of Pseudomonas fluorescens against Pythium aphanidermatum. J. Pure Appl. Microbiol. 2016, 10, 579. [Google Scholar]
- Suresh, P.; Rekha, M.; Gomathinayagam, S.; Ramamoorthy, V.; Sharma, M.P.; Sakthivel, P.; Sekar, K.; Valan Arasu, M.; Shanmugaiah, V. Characterization and assessment of 2, 4-Diacetylphloroglucinol (DAPG)-producing Pseudomonas fluorescens VSMKU3054 for the management of tomato bacterial wilt caused by Ralstonia solanacearum. Microorganisms 2022, 10, 1508. [Google Scholar] [CrossRef]
- Chen, S.C.; Ren, J.J.; Zhao, H.J.; Wang, X.L.; Wang, T.H.; Jin, S.D.; Wang, Z.-H.; Li, C.-Y.; Liu, A.-R.; Lin, X.-M.; et al. Trichoderma harzianum improves defense against Fusarium oxysporum by regulating ROS and RNS metabolism, redox balance, and energy flow in Cucumber roots. Phytopathology 2019, 109, 972–982. [Google Scholar] [CrossRef]
- Pennock, D.; Yates, T.; Braidek, J. Soil sampling design. In Soil sampling and methods of analysis, 2nd ed.; Carter, M.R., Gregorich, E.G., Eds.; Taylor and Francis Group LLC: London, UK, 2006. [Google Scholar]
- Patra, S.K.; Poddar, R. 2023. Evaluation of yield, economics and various indices of water productivity of ginger under flexible moisture regime and nutrient management. J. Crop Weed 2023, 19, 36–42. [Google Scholar] [CrossRef]
- Resham, B.; Amrita, P.; Anish, P.; Bikash, G.; Babu, B.K. Efficacy of different fungicides against rhizome rot disease of ginger under farmer field condition in Salyan, Nepal. Ann. Agric. Crop Sci. 2021, 6, 1093. [Google Scholar]
- Mayee, C.D.; Datar, V.V. Phytopathometry; Tech. Bull-l Marathwada Agric. Univ: Parbhani, India, 1986; p. 66. [Google Scholar]
- Mc Kinney, H.H. A new system of grading plant diseases. J. Agric. Res. 1923, 26, 195–218. [Google Scholar]
- Aamir, S.; Sutar, S.; Singh, S.K.; Baghela, A. A rapid and efficient method of fungal genomic DNA extraction, suitable for PCR based molecular methods. Plant Pathol. Quar. 2015, 5, 74–81. [Google Scholar] [CrossRef]
- White, T.J.; Bruns, T.D.; Lee, S.B.; Taylor, J.W. Amplification and direct sequencing of fungal ribosomal RNA Genes for phylogenetics. In PCR Protocols: A Guide to Methods and Applications; Academic Press: Cambridge, MA, USA, 1990; pp. 315–322. [Google Scholar]
- Villa, N.O.; Kageyama, K.; Asano, T.; Suga, H. Phylogenetic relationships of Pythium and Phytophthora species based on ITS rDNA, cytochrome oxidase II and beta-tubulin gene sequences. Mycologia 2006, 98, 410–422. [Google Scholar]
- Saitou, N.; Nei, M. The neighbor-joining method: A new method for reconstructing phylogenetic trees. Mol. Biol. Evol. 1987, 4, 406–425. [Google Scholar] [PubMed]
- Felsenstein, J. Confidence limits on phylogenies: An approach using the bootstrap. Evolution 1985, 39, 783–791. [Google Scholar] [CrossRef]
- Tamura, K.; Nei, M.; Kumar, S. Prospects for inferring very large phylogenies by using the neighbor-joining method. Proc. Natl. Acad. Sci. USA 2004, 101, 11030–11035. [Google Scholar] [CrossRef]
- Tamura, K.; Stecher, G.; Kumar, S. MEGA 11: Molecular Evolutionary Genetics Analysis Version 11. Mol. Biol. Evol. 2021, 38, 3022–3027. [Google Scholar] [CrossRef] [PubMed]
- Reddy, B.P.; Reddy, K.R.N.; Rao, M.S.; Rao, K.S. Efficacy of antimicrobial metabolites of Pseudomonas fluorescens against rice fungal pathogens. Curr. Trends Biotechnol. Pharm. 2008, 2, 178–182. [Google Scholar]
- Kandoliya, U.; Vakharia, D. Antagonistic effect of Pseudomonas fluorescens against Fusarium oxysporum f. sp. ciceri causing wilt in chickpea. Legume Res. 2013, 36, 569–575. [Google Scholar]
- Gomez, K.A.; Gomez, A.A. Statistical procedures for Agricultural Research, Intl. Rice Res. Inst; John Willy and Sons: New York, NY, USA; Chickester, UK; Brisbane, Australia; Toronto, ON, Canada; Singapore, 1984; p. 643. [Google Scholar]
- Singh, R.A.; Dutta, S.K.; Boopathi, T.; Singh, S.B.; Lungmuana; Saha, S.; Dayal, V.; Anita, P.; Sanajoaba Singh, L. Integrated management of soft rot of ginger in Northeastern hills of India. Indian Phytopathol. 2018, 71, 83–89. [Google Scholar] [CrossRef]
- Chandurkar, R.S.; Apet, K.T.; Patil, A.C.; Lokhande, A.D.; Godhavale, T.S.; Babhare, S.V.; Raner, R.B. Isolation, identification and pathogenicity test of pathogens causing rhizome rot of ginger. Pharma Innov. J. 2022, 11, 5271–5274. [Google Scholar]
- Beakes, G.W.; Thines, M. Hyphochytriomycota and oomycota. In Handbook of the Protists; Springer: Berlin/Heidelberg, Germany, 2017; pp. 435–505. [Google Scholar]
- Timper, P. Conserving and enhancing biological control of nematodes. J. Nematol. 2014, 46, 75–89. [Google Scholar]
- Hashem, A.; Tabassum, B.; Abd_Allah, E.F. Bacillus subtilis: A plant-growth-promoting rhizobacterium that also impacts biotic stress. Saudi J. Biol. Sci. 2019, 26, 1291–1297. [Google Scholar] [CrossRef]
- Kilany, M.; Ibrahim, E.H.; Al Amry, S.; Al Roman, S.; Siddiqi, S. Microbial suppressiveness of Pythium damping-off diseases. In Organic Amendments and Soil Suppressiveness in Plant Disease Management; Meghvansi, M., Varma, A., Eds.; Soil Biology; Springer: Cham, Switzerland, 2015; Volume 46, pp. 187–206. [Google Scholar] [CrossRef]
- Lee, S.J.; Yeo, W.H.; Yun, B.S.; Yoo, I.D. Isolation and sequence analysis of new peptaibol, boletusin, from Boletus spp. J. Pept. Sci. 1999, 5, 374–378. [Google Scholar] [CrossRef]
- Kullnig, C.; Mach, R.L.; Lorito, M.; Kubicek, C.P. Enzyme diffusion from Trichoderma atroviride (=T. harzianum P1) to Rhizoctonia solani is a prerequisite for triggering of Trichoderma ech42 gene expression before mycoparasitic contact. Appl. Environ. Microbiol. 2000, 66, 2232–2234. [Google Scholar]
- Meena, M.; Swapnil, P.; Zehra, A.; Dubey, M.K.; Upadhyay, R. Antagonistic assessment of Trichoderma spp. by producing volatile and non-volatile compounds against different fungal pathogens. Arch Phytopathol. Plant Prot. 2017, 50, 629–648. [Google Scholar] [CrossRef]
- Anoop, K.; Suseela Bhai, R. Evaluation of antagonistic potential of indigenous Trichoderma isolates against Pythium aphanidermatum (Edson) Fitz. Causing rhizome rot in turmeric (Curcuma longa L). J. Sci. 2014, 4, 99–105. [Google Scholar]
- Shanmugam, V.; Varma, A.S.; Surendran, M. Management of rhizome rot of ginger by antagonistic microorganisms. Madras Agric. J. 1999, 86, 341–342. [Google Scholar]
- Thakur, A.; Thakur, N.; Dohroo, N.P. Rhizome rot of ginger-management through non-chemical approach. Int. J. Plant Prot. 2017, 10, 140–145. [Google Scholar] [CrossRef]
- Sinha, A. Rhizome rot disease of ginger (Zingiber officinale Rosc.) and its bio-control strategy. Sci. Temper 2020, 11, 95–99. [Google Scholar]
- Lalfakawma, C.; Nath, B.C.; Bora, L.C.; Srivastava, S.; Singh, J.P. Integrated disease management of Zingiber officinale Rosc. rhizome rot. Bioscan 2014, 9, 265–269. [Google Scholar]
- Ushamalini, C.; Arunkumar, K.; Mohanalakshmi, M. Beneficial microbial application for the management of ginger rhizome rot. J. Pharmacogn. Phytochem. 2019, 8, 430–432. [Google Scholar]
- Matsumoto, A.; Takahashi, Y. Endophytic Actinomycetes: Promising Source of Novel Bioactive Compounds. J. Antibiot. 2017, 70, 514–519. [Google Scholar] [CrossRef]
- Silva, R.N.; Monteiro, V.N.; Steindorff, A.S.; Gomes, E.V.; Noronha, E.F.; Ulhoa, C.J. Trichoderma/pathogen/plant interaction in pre-harvest food security. Fungal Biol. 2019, 123, 565–583. [Google Scholar] [CrossRef]
- Ezrari, S.; Mhidra, O.; Radouane, N.; Tahiri, A.; Polizzi, G.; Lazraq, A.; Lahlali, R. Potential role of Rhizobacteria isolated from citrus rhizosphere for biological control of citrus dry root rot. Plants 2021, 10, 872. [Google Scholar] [CrossRef]
- Ayaz, M.; Ali, Q.; Farzand, A.; Khan, A.R.; Ling, H.; Gao, X. Nematicidal volatiles from Bacillus atrophaeus GBSC56 promote growth and stimulate induced systemic resistance in tomato against Meloidogyne incognita. Int. J. Mol. Sci. 2021, 22, 5049. [Google Scholar] [CrossRef]
- Zubair, M.; Hanif, A.; Farzand, A.; Sheikh, T.M.M.; Khan, A.R.; Suleman, M.; Ayaz, M.; Gao, X. Genetic screening and expression analysis of Psychrophilic Bacillus spp. reveal their potential to alleviate cold stress and modulate phytohormones in wheat. Microorganisms 2019, 7, 337. [Google Scholar] [CrossRef]
- Sutthisa, W.; Hompana, W.; Yutthasin, R. Enhancing biocontrol potential: Development and efficacy assessment of a liquid formulation of Trichoderma asperellum MSU007 against Sclerotium rolfsii. Trends Sci. 2024, 21, 7550. [Google Scholar] [CrossRef]
- Mall, M.; Kumar, R.; Akhtar, M.Q. Horticultural crops and abiotic stress challenges. In Stress Tolerance in Horticultural Crops; Woodhead Publishing: Cambridge, UK, 2021; pp. 1–19. [Google Scholar]
- Meena, K.R.; Kanwar, S.S. Lipopeptides as the antifungal and antibacterial agents: Applications in food safety and therapeutics. BioMed Res. Int. 2015, 2015, 473050. [Google Scholar] [CrossRef] [PubMed]
- Chavan, P.G.; Apet, K.T.; Borade, R.S. Efficacy of fungicides and bioagents against Pythium aphanidermatum causing rhizome rot of turmeric. Int. J. Curr. Microbiol. App. Sci. 2017, 6, 4312–4320. [Google Scholar] [CrossRef]
- Bhai, S.R.; Kishore, V.K.; Kumar, A.; Anandaraj, M.E.; Santhosh, J. Screening of rhizobacterial isolates against soft rot disease of ginger (Zingiber officinale Rosc.). J. Spices Aromat. Crops 2005, 14, 130–136. [Google Scholar]
- Dohroo, N.P.; Kansal, S.; Ahluwalia, N. Studies on eco-farmer-friendly practices for management of soft rot of ginger (Zingiber officinale). Indian Phytopathol. 2015, 68, 93–96. [Google Scholar]
- Sagar, S.D. Investigations on the Etiology, Epidemiology and Integrated Management of Rhizome Rot Complex of Ginger and Turmeric. Ph.D. Thesis, University of Agriculture, Dharwad, Indian, 2006. [Google Scholar]
- Pavitra, G.N.B.; Joshi, R.; Meghana, S.P.; Naik, M.K.; Satish, K.M.; Nandish, M.S. In vitro evaluation of Trichoderma spp. against Pythium myriotylum and Pythium aphanidermatum. Pharma Innov. J. 2022, 11, 25–29. [Google Scholar]
- Chaithra1, J.; Kulkarni, S.; Sunkad, G.; Amresh, Y.S.; Patil, S. In vitro efficacy of fungicides and bioagents for the management of soft rot of ginger caused by Pythium aphanidermatum. Int. J. Curr. Microbiol. Appl. Sci. 2019, 8, 3007–3015. [Google Scholar] [CrossRef]
- Karnewar, A.B.; Pawar, G.S.; Salunke, D.V. In vitro efficacy of selected potential bioagents against soil borne pathogen Pythium aphanidermatum. Pharma Innov. 2022, 11, 2174–2178. [Google Scholar]
- Lokesh, M.S.; Patil, S.V.; Gurumurthy, S.B.; Palakshappa, M.G.; Anandaraj, M. Efficacy of Pseudomonas fluorescens in relation to diseases incidence of soft rot of ginger in Uttara Kannada district of Karnataka. Int. J. Plant Prot. 2013, 6, 221–222. [Google Scholar]
- Tripathi, A.K.; Singh, A.K. Effects of Trichoderma viride and copper hydroxide on rhizome rot of ginger. Bangladesh J. Bot. 2021, 50, 45–49. [Google Scholar] [CrossRef]
- Bhagade, A.S.; Gupta, V.R.; Dabhadkar, V.B.; Patil, S.S.; Dhanorkar, V.P. In vitro efficacy of fungicides and bio-agents against Pythium aphanidermatum causing rhizome rot of ginger. Int. J. Adv. Biochem. Res. 2024, 8, 731–734. [Google Scholar] [CrossRef]
- Godase, N.N.; Dandnaik, B.P.; Shinde, P.A.; Markad, H.N.; More, A.S. In vitro efficacy of bio-agents against Pythium aphanidermatum causing rhizome soft rot of ginger. Pharma Innov. J. 2023, 12, 1099–1102. [Google Scholar]
- Singh, T.S.; Singh, Y.H.; Devi, P.S.; Sinha, B.; Singh, N.G.; Chanu, N.T. In vivo efficacy of different native Trichoderma isolates and fungicides against rhizome rot of ginger in Manipur. Pharma Innov. J. 2023, 12, 1754–1758. [Google Scholar]
- Singh, H.K.; Prakash, N.; Ray, P.K.; Singh, P.; Saha, B.N.; Singh, R.; Roy, M.K.; Kumar, A.; Kumar, A. Yield maximization in ginger through management of ginger (Zingiber officinale Roscoe) rhizome rot. Pharma Innov. J. 2023, 12, 1230–1232. [Google Scholar]
- Ravi, A.; Varghese, S.; Krishnankutty, E.R. Biocontrol activity of the extract prepared from Zingiber zerumbet for the management of rhizome rot in Zingiber officinale caused by Pythium myriotylum. Arch. Phytopathol. Plant Prot. 2017, 50, 555–567. [Google Scholar] [CrossRef]
- Yadav, D.; Gaurav, H.; Yadav, R.; Waris, R.; Afzal, K.; Shukla, A.C. A comprehensive review on soft rot disease management in ginger (Zingiber officinale) for enhancing its pharmaceutical and industrial values. Heliyon 2023, 9, e18337. [Google Scholar] [CrossRef]
- Behera, S.; Sial, P.; Pradhan, K.S. Management of rhizome rot disease of ginger. J. Soils Crops 2018, 28, 323–325. [Google Scholar]
- Sood, M.; Kapoor, D.; Kumar, V.; Sheteiwy, M.S.; Ramakrishnan, M.; Landi, M.; Araniti, F.; Sharma, A. Trichoderma: The “Secrets” of a Multitalented Biocontrol Agent. Plants 2020, 9, 762. [Google Scholar] [CrossRef] [PubMed]
- Kushwaha, S.S.; Gupta, P.G.; Gharde, Y. Impact of biocontrol agents and its combination for management of rhizome rot of ginger. Ann. Plant Prot. Sci. 2023, 31, 28–34. [Google Scholar] [CrossRef]
- Valloppilli, A.J.; Latheef, V.A.; Puthenpurayi, R.; Rajesh, K.P. Efficacy of indigenous Trichoderma isolates against Pythium deliense Meurs, associated with soft rot of ginger. J. Crop Prot. 2024, 13, 101–113. [Google Scholar]
- Romera, F.J.; García, M.J.; Lucena, C.; Martínez-Medina, A.; Aparicio, M.A.; Ramos, J.; Alcántara, E.; Angulo, M.; Pérez-Vicente, R. Induced systemic resistance (ISR) and Fe deficiency responses in dicot plants. Front. Plant Sci. 2019, 10, 287. [Google Scholar] [CrossRef]

| Soil Properties | 0–30 cm Depth |
|---|---|
| pH | 5.01 |
| EC (ds/m) | 0.82 |
| SOC (%) | 0.556 |
| N (kg/ha) | 245 |
| P (kg/ha) | 22.4 |
| K (kg/ha) | 102 |
| S (ppm) | 22.6 |
| Mn (ppm) | 28 |
| B (ppm) | 0.86 |
| Fe (ppm) | 23.58 |
| Cu (ppm) | 0.22 |
| Zn (ppm) | 0.86 |
| Severity Scale | Rating Grade (%) | Level of Resistance/Susceptibility |
|---|---|---|
| 0 | 0 | No infection on rhizome |
| 1 | 0.1–5.0 | 0.1–5.0% rotting of rhizome |
| 2 | 5.1–15.0 | 5.1–15.0% rotting of rhizome |
| 3 | 15.1–30.0 | 15.1–30.0% rotting of rhizome |
| 4 | 30.1–60.0 | 30.1–60.0% rotting or rhizome |
| 5 | More than 60 | More than 60% rotting of rhizome. |
| Treatments | Rhizome Germination (%) | Plant Height (cm) at 152 DAS | Disease Incidence (%) | PDI | ||||||||
|---|---|---|---|---|---|---|---|---|---|---|---|---|
| 32 DAS | 62 DAS | 92 DAS | 122 DAS | 152 DAS | 32 DAS | 62 DAS | 92 DAS | 122 DAS | 152 DAS | |||
| T1 | 81.67 d | 55.10 e | 16.50 b | 24.33 b | 22.33 b | 19.33 b | 16.50 b | 8.47 b | 15.98 ab | 13.91 b | 10.50 b | 7.85 b |
| T2 | 83.17 cd | 57.33 d | 16.17 b | 24.00 b | 21.50 b | 18.50 b | 15.00 bc | 8.06 b | 15.40 b | 12.87 bc | 9.71 bc | 6.81 bc |
| T3 | 85.67 bc | 59.93 b | 15.83 b | 22.33 cd | 18.83 cd | 15.83 cd | 13.33 c | 7.59 b | 14.63 cd | 11.77 de | 8.82 cd | 6.10 d |
| T4 | 84.33 bcd | 58.85 c | 15.67 b | 23.83 bc | 20.83 bc | 17.83 bc | 15.17 bc | 7.59 b | 13.64 bc | 10.72 cd | 7.92 bc | 5.32 cd |
| T5 | 86.83 b | 60.13 b | 13.67 c | 21.00 d | 18.17 d | 14.50 d | 10.83 d | 5.67 c | 12.92 d | 9.90 e | 6.34 d | 3.39 e |
| T6 | 91.83 a | 61.38 a | 12.50 c | 19.00 e | 15.17 e | 11.00 e | 8.17 e | 4.90 c | 10.89 e | 7.86 f | 4.22 e | 1.93 f |
| T7 | 74.33 e | 52.77 f | 18.33 c | 26.00 a | 32.00 a | 38.50 a | 46.83 a | 10.21 a | 17.63 a | 22.70 a | 29.11 a | 38.12 a |
| LSD (p ≤ 0.05) | 2.86 | 1.07 | 1.43 | 1.59 | 1.69 | 1.84 | 1.88 | 1.57 | 1.32 | 1.62 | 2.04 | 1.84 |
| pH | Electrical Conductivity (dS/m) | Soil Organic Carbon (%) | Av. Nitrogen (Kg/ha) | Av. Phosphorus (Kg/ha) | Av. Potassium (Kg/ha) | Disease Severity | |
|---|---|---|---|---|---|---|---|
| pH | 1 | −0.991 ** | 0.981 ** | 0.966 ** | 0.926 ** | 0.886 ** | −0.522 ** |
| Electrical Conductivity (dS/m) | 1 | −0.976 ** | −0.958 ** | −0.907 ** | −0.898 ** | 0.508 ** | |
| Soil Organic carbon (%) | 1 | 0.989 ** | 0.966 ** | 0.805 ** | −0.555 ** | ||
| Av. Nitrogen (Kg/ha) | 1 | 0.986 ** | 0.760 ** | −0.600 ** | |||
| Av. Phosphorus (Kg/ha) | 1 | 0.669 ** | −0.631 ** | ||||
| Av. Potassium (Kg/ha) | 1 | −0.273 * | |||||
| Disease Severity | 1 |
| Sl No. | Bio Agent/Fungicide (COC) | Percent Inhibition of Mycelial Growth (%) |
|---|---|---|
| 1 | Trichoderma harzianum | 65.5 |
| 3 | Pseudomonas fluorescens | 60.2 |
| 4 | COC 1500 ppm | 90.7 |
| 5 | COC 2000 ppm | 94.2 |
| Treatments | Gross Cost of Cultivation (Rs/ha) | CODEX (%) | Rhizome Yield (t/ha) * | % Increase over Control | RRYL | Gross Income ** (Rs.) | Additional Income/ha over Control | Net Profit (Rs.) | B:C Ratio | |||
|---|---|---|---|---|---|---|---|---|---|---|---|---|
| Cost of Cultivation | Treatments | Labour Charges | Total (Rs.) | |||||||||
| T1 | 112,700 | 3735 | 1000 | 117,435 | 1.81 | 8.15 | 9.01 | 8.26 | 448,158 | 36,850 | 330,723 | 1:2.82 |
| T2 | 112,700 | 3675 | 1000 | 117,375 | 1.60 | 8.35 | 11.69 | 10.46 | 459,250 | 47,942 | 341,875 | 1:2.91 |
| T3 | 112,700 | 3870 | 1000 | 117,570 | 1.45 | 8.55 | 14.41 | 12.57 | 469,975 | 58,667 | 352,405 | 1:3.00 |
| T4 | 112,700 | 6860 | 3000 | 122,560 | 1.20 | 8.68 | 15.98 | 13.75 | 477,583 | 66,275 | 355,023 | 1:2.90 |
| T5 | 112,700 | 6972 | 3000 | 122,672 | 0.89 | 9.10 | 21.85 | 17.91 | 500,592 | 89,283 | 377,920 | 1:3.08 |
| T6 | 112,700 | 10,020 | 3000 | 125,720 | 0.55 | 9.36 | 25.19 | 20.10 | 514,525 | 103,217 | 388,805 | 1:3.09 |
| T7 | - | - | - | 112,700 | 6.76 | 7.48 | - | - | 411,308 | - | 298,608 | 1:2.65 |
| S.Em. (±) | - | - | - | - | - | 0.48 | - | - | - | - | - | - |
| C.D. (p = 0.05) | - | - | - | - | - | 1.47 | - | - | - | - | - | - |
Disclaimer/Publisher’s Note: The statements, opinions and data contained in all publications are solely those of the individual author(s) and contributor(s) and not of MDPI and/or the editor(s). MDPI and/or the editor(s) disclaim responsibility for any injury to people or property resulting from any ideas, methods, instructions or products referred to in the content. |
© 2025 by the authors. Licensee MDPI, Basel, Switzerland. This article is an open access article distributed under the terms and conditions of the Creative Commons Attribution (CC BY) license (https://creativecommons.org/licenses/by/4.0/).
Share and Cite
Dey, U.; Sarkar, S.; Awasthi, D.P.; Sehgal, M.; Kumar, R.; De, B.; Adhikary, N.K.; Debnath, A.; Tiwari, R.K.; Lal, M.K.; et al. Identification, Detection, and Management of Soft Rot Disease of Ginger in the Eastern Himalayan Region of India. Pathogens 2025, 14, 544. https://doi.org/10.3390/pathogens14060544
Dey U, Sarkar S, Awasthi DP, Sehgal M, Kumar R, De B, Adhikary NK, Debnath A, Tiwari RK, Lal MK, et al. Identification, Detection, and Management of Soft Rot Disease of Ginger in the Eastern Himalayan Region of India. Pathogens. 2025; 14(6):544. https://doi.org/10.3390/pathogens14060544
Chicago/Turabian StyleDey, Utpal, Shatabhisa Sarkar, Durga Prasad Awasthi, Mukesh Sehgal, Ravinder Kumar, Biman De, Nayan K. Adhikary, Abhijit Debnath, Rahul Kumar Tiwari, Milan Kumar Lal, and et al. 2025. "Identification, Detection, and Management of Soft Rot Disease of Ginger in the Eastern Himalayan Region of India" Pathogens 14, no. 6: 544. https://doi.org/10.3390/pathogens14060544
APA StyleDey, U., Sarkar, S., Awasthi, D. P., Sehgal, M., Kumar, R., De, B., Adhikary, N. K., Debnath, A., Tiwari, R. K., Lal, M. K., Chander, S., Sharma, P. R., & Mohanty, A. K. (2025). Identification, Detection, and Management of Soft Rot Disease of Ginger in the Eastern Himalayan Region of India. Pathogens, 14(6), 544. https://doi.org/10.3390/pathogens14060544

